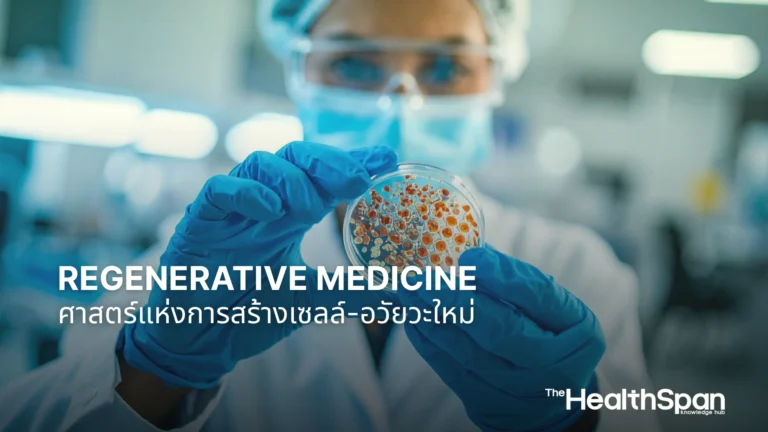
Regenerative Medicine ศาสตร์แห่งการสร้างเซลล์และอวัยวะใหม่

เคยจินตนาการถึงโลกที่ร่างกายของเรา สามารถซ่อมแซมตัวเองได้อย่างน่าอัศจรรย์ไหม? โลกที่เราไม่ต้องทนทุกข์กับอวัยวะที่เสื่อมสภาพ หรือรอคอยการปลูกถ่ายอวัยวะที่แสนยาวนาน? ฟังดูเหมือนเป็นพล็อตหนังวิทยาศาสตร์ แต่ในความเป็นจริงแล้ว สิ่งเหล่านี้กำลังจะกลายเป็นจริงได้ด้วย Regenerative Medicine หรือ “เวชศาสตร์ฟื้นฟู” นั่นเอง
Regenerative Medicine คือนวัตกรรมทางการแพทย์ ที่กำลังปฏิวัติการรักษาโรคต่าง ๆ ด้วยการกระตุ้นให้ร่างกายของเรา มีความสามารถในการสร้างอวัยวะใหม่ หรือซ่อมแซมเนื้อเยื่อที่เสียหาย ขึ้นมาทดแทนได้เอง เพื่อซ่อมแซมร่างกายที่เสื่อมสภาพ หรือรักษาโรคเรื้อรังที่เคยไร้ทางรักษา The HealthSpan จะพาคุณไปทำความรู้จักกับโลกแห่งเวชศาสตร์ฟื้นฟู ที่เต็มไปด้วยความหวังนี้กัน
Regenerative Medicine คืออะไร หลักการแห่ง เวชศาสตร์ฟื้นฟู
Regenerative Medicine คือสาขาการแพทย์ที่เน้นการฟื้นฟู ซ่อมแซม หรือสร้าง เซลล์ เนื้อเยื่อ หรืออวัยวะที่เสียหาย หรือทำงานผิดปกติขึ้นมาใหม่ เพื่อฟื้นฟูการทำงานของอวัยวะเหล่านั้น ให้กลับมาเป็นปกติ เป้าหมายสูงสุดของเวชศาสตร์ฟื้นฟู คือการช่วยให้ร่างกายสามารถรักษาตัวเองได้ และไม่ต้องพึ่งพาการปลูกถ่ายอวัยวะจากภายนอก ซึ่งมีความเสี่ยงจากการปฏิเสธเนื้อเยื่อและการขาดแคลนอวัยวะ
หลักการสำคัญของ Regenerative Medicine คือการใช้ความสามารถตามธรรมชาติของร่างกาย ในการซ่อมแซมตัวเอง ซึ่งเราทุกคนต่างก็มีกลไกนี้อยู่แล้ว เช่น เมื่อเราโดนมีดบาด ผิวหนังก็จะสมานกันเอง หรือเมื่อกระดูกหัก ร่างกายก็จะสร้างกระดูกใหม่ขึ้นมาเชื่อมต่อ แต่วิธีการนี้จะไปเสริมสร้างและเร่งกระบวนการซ่อมแซมเหล่านั้น ให้มีประสิทธิภาพมากขึ้น หรือแม้กระทั่ง “เริ่มต้น” การสร้างอวัยวะใหม่ตั้งแต่ต้นเลยทีเดียว
ลองนึกภาพว่า ถ้าคุณมีโรคเบาหวานขั้นรุนแรง ที่ตับอ่อนไม่สามารถผลิตอินซูลินได้เลย แทนที่จะต้องฉีดอินซูลินไปตลอดชีวิต Regenerative Medicine อาจจะช่วยให้คุณสามารถ “สร้าง” เซลล์ตับอ่อนใหม่ที่ทำงานได้ปกติขึ้นมาทดแทนได้ นี่คือความหวังอันยิ่งใหญ่ที่วงการแพทย์กำลังมุ่งไป
หัวใจสำคัญของ Regenerative Medicine สเต็มเซลล์ และ Tissue Engineering
หัวใจหลักที่ขับเคลื่อน Regenerative Medicine ให้ก้าวหน้าคือ เทคโนโลยีที่เกี่ยวข้องกับ “สเต็มเซลล์” และ “วิศวกรรมเนื้อเยื่อ” หรือ “Tissue Engineering”
1. สเต็มเซลล์ (Stem Cells)
สเต็มเซลล์ หรือเซลล์ต้นกำเนิด คือ “เซลล์มหัศจรรย์” ที่มีคุณสมบัติพิเศษสองอย่างที่สำคัญที่สุด สำหรับ เวชศาสตร์ฟื้นฟู
- ความสามารถในการแบ่งตัวและเพิ่มจำนวน สเต็มเซลล์สามารถสร้างเซลล์ ที่เป็นชนิดเดียวกันเพิ่มขึ้นได้เรื่อย ๆ
- ความสามารถในการเปลี่ยนไปเป็นเซลล์ชนิดอื่น นี่คือจุดที่น่าทึ่งที่สุด สเต็มเซลล์สามารถพัฒนาไปเป็นเซลล์ที่ทำหน้าที่เฉพาะเจาะจงได้หลากหลายชนิด เช่น เซลล์ผิวหนัง เซลล์กระดูก เซลล์หัวใจ หรือเซลล์ประสาท
ใน Regenerative Medicine เราสามารถนำสเต็มเซลล์ ที่ได้จากแหล่งต่าง ๆ เช่น ไขกระดูก ไขมัน หรือเลือดสายสะดือของผู้ป่วยเอง มาเพาะเลี้ยงและเพิ่มจำนวนในห้องปฏิบัติการ จากนั้นจึงนำไปใช้เพื่อ
- ฉีดกลับเข้าไปในบริเวณที่เสียหาย เพื่อให้สเต็มเซลล์เหล่านั้น ไปกระตุ้นการซ่อมแซม หรือเปลี่ยนไปเป็นเซลล์ที่เสียหาย
- สร้างเนื้อเยื่อหรืออวัยวะในห้องทดลอง โดยใช้สเต็มเซลล์เป็นวัตถุดิบหลัก
การสร้างอวัยวะใหม่ด้วยสเต็มเซลล์ จึงเป็นการพลิกโฉมการรักษาโรค โดยเฉพาะโรคที่เกิดจากการเสื่อมสภาพของเซลล์หรือเนื้อเยื่อ เช่น ข้อเข่าเสื่อม เบาหวาน หรือโรคหัวใจ
2. วิศวกรรมเนื้อเยื่อ (Tissue Engineering)
วิศวกรรมเนื้อเยื่อ เป็นอีกหนึ่งเสาหลักของ Regenerative Medicine โดยเป็นใช้หลักการทางวิศวกรรมและชีววิทยา เพื่อสร้างหรือซ่อมแซมเนื้อเยื่อที่เสียหาย ขึ้นมาใหม่ในห้องปฏิบัติการ โดยมีองค์ประกอบสำคัญ 3 อย่างคือ
- เซลล์ (Cells) โดยเฉพาะอย่างยิ่งสเต็มเซลล์
- โครงสร้างค้ำจุน (Scaffold) เป็นเหมือนโครงกระดูก ที่ทำหน้าที่เป็นที่ยึดเกาะและชี้นำ ให้เซลล์เติบโตและจัดเรียงตัว เป็นรูปร่างของเนื้อเยื่อหรืออวัยวะนั้น ๆ โครงสร้างนี้มักทำจากวัสดุชีวภาพที่เข้ากันได้กับร่างกาย
- สารชีวภาพ (Growth Factors/Bioactive Molecules) สารเหล่านี้จะช่วยกระตุ้นให้เซลล์เติบโต แบ่งตัว และพัฒนาไปเป็นเนื้อเยื่อที่ต้องการ
เมื่อนำทั้งสามองค์ประกอบมารวมกัน นักวิทยาศาสตร์สามารถ “สร้าง” เนื้อเยื่อหรืออวัยวะขนาดเล็กขึ้นมาในห้องทดลองได้ เช่น กระดูกอ่อน ผิวหนัง หรือแม้แต่หลอดเลือด จากนั้นจึงนำไปปลูกถ่ายให้กับผู้ป่วย
การสร้างอวัยวะใหม่ ในห้องทดลอง จากความฝันสู่ความเป็นจริง
จากความก้าวหน้าของสเต็มเซลล์และวิศวกรรมเนื้อเยื่อ ทำให้แนวคิดเรื่องการสร้างอวัยวะใหม่ ไม่ได้เป็นเพียงความฝันอีกต่อไป แต่กำลังก้าวเข้าสู่ความเป็นจริงอย่างรวดเร็ว
ปัจจุบันมีงานวิจัยและเทคโนโลยีที่น่าทึ่งเกิดขึ้นมากมาย
- การสร้างผิวหนังทดแทน สำหรับผู้ป่วยแผลไฟไหม้รุนแรง นักวิทยาศาสตร์สามารถนำเซลล์ผิวหนังของผู้ป่วย มาเพาะเลี้ยงและสร้างเป็นแผ่นผิวหนังขนาดใหญ่ เพื่อปลูกถ่ายได้แล้ว (แหล่งอ้างอิง: American Academy of Dermatology)
- กระดูกอ่อนและกระดูก มีการใช้สเต็มเซลล์และโครงสร้างค้ำจุน เพื่อสร้างกระดูกอ่อนสำหรับข้อต่อ หรือกระดูกสำหรับผู้ป่วยที่มีกระดูกหักรุนแรง
- หลอดเลือด มีการทดลองสร้างหลอดเลือดขนาดเล็ก ในห้องทดลองเพื่อใช้ในการปลูกถ่าย
- อวัยวะที่ซับซ้อนขึ้น กำลังมีการวิจัยและพัฒนา การสร้างอวัยวะใหม่ ที่ซับซ้อนขึ้น เช่น กระเพาะปัสสาวะ หลอดลม หรือแม้แต่หัวใจและตับขนาดเล็ก โดยใช้เทคโนโลยี 3D Bio-printing ที่สามารถ “พิมพ์” อวัยวะออกมาเป็นชั้น ๆ จากเซลล์ของผู้ป่วยเอง ซึ่งจะช่วยลดปัญหาการปฏิเสธเนื้อเยื่อได้อย่างมาก
แม้ว่าการสร้างอวัยวะขนาดใหญ่ ที่ทำงานได้สมบูรณ์แบบยังคงเป็นความท้าทาย แต่ความก้าวหน้าเหล่านี้ก็เป็นสัญญาณที่ดีว่า อนาคตที่เราสามารถมี “อวัยวะอะไหล่” ที่สร้างขึ้นจากเซลล์ของเราเองนั้น อยู่ไม่ไกลเกินเอื้อม
Regenerative Medicine กับอนาคตการรักษาโรคเสื่อม และความเสียหายของอวัยวะ
Regenerative Medicine กำลังกลายเป็นความหวังใหม่ ในการรักษาโรคเสื่อม และความเสียหายของอวัยวะ ที่เคยเป็นข้อจำกัดทางการแพทย์มาโดยตลอด
- โรคเบาหวาน เป้าหมายคือการ สร้างอวัยวะใหม่ เช่น เซลล์ตับอ่อนที่ผลิตอินซูลินได้ปกติ เพื่อรักษาโรคเบาหวานประเภท 1
- โรคหัวใจ การใช้สเต็มเซลล์ เพื่อซ่อมแซมกล้ามเนื้อหัวใจ ที่เสียหายหลังภาวะหัวใจวาย
- โรคระบบประสาท เช่น พาร์กินสัน อัลไซเมอร์ หรือการบาดเจ็บไขสันหลัง โดยใช้สเต็มเซลล์ เพื่อซ่อมแซมหรือเปลี่ยนเซลล์ประสาทที่เสียหาย
- โรคข้อเข่าเสื่อม การใช้สเต็มเซลล์หรือวิศวกรรมเนื้อเยื่อ เพื่อฟื้นฟูหรือสร้างกระดูกอ่อนข้อเข่าขึ้นมาใหม่
- ความเสียหายของอวัยวะอื่น ๆ ไม่ว่าจะเป็นไต ตับ หรือปอด ที่ได้รับความเสียหายจากโรคหรืออุบัติเหตุ
ด้วยศักยภาพอันมหาศาลนี้ Regenerative Medicine จะพลิกโฉมการดูแลสุขภาพของเรา จากการ “รักษาอาการ” ไปสู่การ “ฟื้นฟูและสร้างใหม่” อย่างแท้จริง ทำให้ผู้ป่วยมีโอกาสกลับมามีคุณภาพชีวิตที่ดีขึ้น และมีสุขภาพที่สมบูรณ์แข็งแรงได้อีกครั้ง
Regenerative Medicine ไม่ใช่แค่แนวคิดในจินตนาการ แต่คือกำลังหลัก ในการก้าวไปข้างหน้าของวงการแพทย์ การทำความเข้าใจว่า Regenerative Medicine คืออะไร และหลักการของเวชศาสตร์ฟื้นฟู ที่อาศัยพลังของสเต็มเซลล์และวิศวกรรมเนื้อเยื่อ ทำให้เราเห็นถึงความหวังใหม่ ในการสร้างอวัยวะใหม่ เพื่อ ซ่อมแซมร่างกาย และรักษาโรคเสื่อมที่เคยเป็นไปไม่ได้
อนาคตที่ร่างกายสามารถฟื้นฟูตัวเองได้อย่างสมบูรณ์แบบ กำลังรออยู่ข้างหน้า และ Regenerative Medicine คือกุญแจสำคัญ ที่จะเปิดประตูสู่โลกใบนั้น มาร่วมติดตามความก้าวหน้า ของนวัตกรรมทางการแพทย์อันน่าทึ่งนี้ไปด้วยกัน
——————–
แหล่งข้อมูลอ้างอิง
- American Academy of Dermatology (AAD): “Skin Grafts.”
- Mayo Clinic: “Regenerative medicine: How it works, uses, and risks.”
- National Institutes of Health (NIH) – National Institute of Biomedical Imaging and Bioengineering (NIBIB): “Tissue Engineering & Regenerative Medicine.”